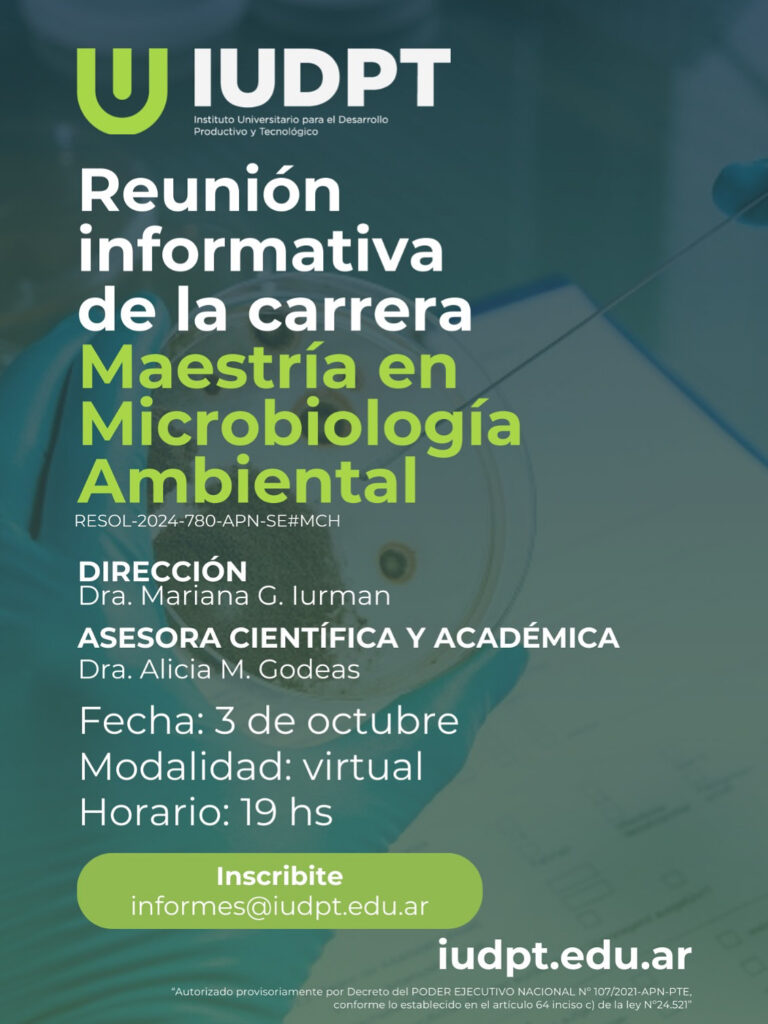

19 de Septiembre / 2025
🔬 Charla Informativa IUDPT
El IUDPT te invita a participar de una charla informativa sobre la Maestría en Microbiología Ambiental. La Directora, Dra. Mariana Iurman, y la Asesora Científica y Académica, Dra. Alicia Godeas, presentarán este programa de formación avanzada, orientado a profesionales interesados en el análisis y la aplicación de microorganismos en diferentes ámbitos.
En el encuentro se expondrá sobre el plan de estudios y su orientación hacia cómo la microbiología ambiental constituye una herramienta fundamental para la biorremediación y el desarrollo de productos microbianos que favorecen la producción agrícola.
La maestría se dirige a quienes buscan especializarse microbiología aplicada, brindando una preparación sólida para el liderazgo de proyectos o la creación de empresas de base microbiológica.
Más información: [email protected] | 11-4144-4027